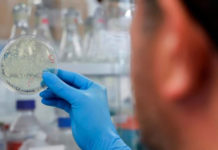
Descubrieron el “talón de Aquiles” del coronavirus para evitar que se multiplique en el cuerpo

Vacuna de Moderna «altamente efectiva» en adolescentes contra COVID-19
La farmacéutica Moderna anunció que su vacuna contra COVID-19...
Descubrieron el “talón de Aquiles” del coronavirus para evitar que se multiplique en el...
Investigadores suizos e irlandeses hallaron un mecanismo por el...
¿Qué tan eficaces son las vacunas contra la COVID-19?
El mundo afronta desde finales de diciembre la campaña...
Cómo funciona la vacuna de Johnson & Johnson
Johnson & Johnson está probando una vacuna contra el...
Rusia aprobó el control de calidad para la Sputnik V producida en la Argentina
Así lo informó la ministra de Salud al referise...
Coronavirus: la Sputnik V genera anticuerpos contra la variante de Manaos
Un estudio realizado por investigadores argentinos constató que a...
¿Se debe vacunar a los que superaron el COVID-19?
¿Tiene sentido que las personas que se contagiaron con...
Faltan 6 millones de enfermeros en el mundo.
Advertencia sobre la fuga de cerebros del mundo en...
Científicos descubrieron que la inmunidad al coronavirus podría durar años
Dos estudios concluyeron que las células inmunes importantes sobreviven...
CureVac: por qué esta vacuna alemana se puede convertir en la esperanza para el...
Producida por Alemania bajo la tecnología ARN Mensajero, está...